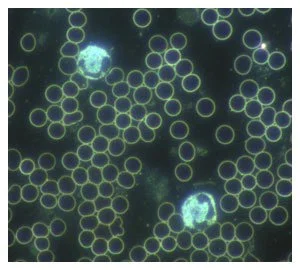

Dunkelfeld-Mikroskopie
Die Dunkelfeldmikroskopie ist eine optische Methode der Blutuntersuchung. Es handelt sich um eine spezielle Variante der Lichtmikroskopie, bei der Blut ohne vorherige Färbung untersucht werden kann.

Dunkelfeldmikroskopie
Wir haben heute eine Vielzahl von chronischen Erkrankungen (Rheuma, Diabetes Typ 2, Autoimmunkrankheiten, Krebs, Parkinson, MS, Fibromyalgie, Allergien etc.), bei denen es in der Schulmedizin keine kausalen Therapien gibt, die zur Heilung führen.
Durch die Dunkelfeldmikroskopie können Ursachen herausgefunden und therapeutische Maßnahmen eingeleitet werden, die dazu beitragen können, den Körper wieder in sein ursprüngliches Gleichgewicht zurückzuführen.
Was Ist Dunkelfeldmikroskopie ?
Die Dunkelfeldmikroskopie ist eine optische Methode der Blutuntersuchung. Es handelt sich um eine spezielle Variante der Lichtmikroskopie, bei der Blut ohne vorherige Färbung untersucht werden kann.
Durch die Färbung werden die Blutzellen normalerweise abgetötet. Bei der Dunkelfeldmikroskopie hingegen schauen wir uns anhand eines einzigen Blutstropfens das ganz lebendige und vitale Blut an. Auf diese Weise kann der Gesundheitszustand eines Menschen analysiert werden.
Über eine an das Mikroskop angeschlossene Kamera ist es Ihnen möglich, Ihr Blut selbst mitzubetrachten.
Aus dieser speziellen Blutdiagnostik ergeben sich die individuellen Therapieempfehlungen.

Was kann mittels des Dunkelfeldmikroskops festgestellt werden ?
Man kann mittels des Dunkelfeldmikroskops die Quantität der verschiedenen Blutzellen bestimmen, als auch Aussagen über die Aktivität und Funktionstüchtigkeit unserer Blutbestandteile treffen.
Da drei Viertel unseres Körpers aus Flüssigkeit bestehen, können wir mit dieser Methode der Betrachtung den Zustand des Organismus zu einem ganz erheblichen Teil beurteilen. Wir erkennen vor allem das Millieu, das jede unserer Zellen umgibt und das die Grundlage bildet für Gesundheit oder Krankheit unserer Organe und Organsysteme.
Desweiteren können Zeichen der Übersäuerung, Candida, verschiedene Organbelastungen, Durchblutungsstörungen, versteckte Krankheitsursachen wie z.B. mikrobielle als auch toxische Belastungen u.a. festgestellt werden.

Dunkelfeldmikroskopie und Enderlein
Die Untersuchung des Nativblutes Im Dunkelfeldmikroskop wurde von dem Zoologen und Bakteriologen Prof. Dr. Günther Enderlein (1872 – 1968) entwickelt.
Ein wesentliches Ergebnis der Forschung Enderleins war die Erkenntnis, dass es im menschlichen und tierischen Körper eine Symbiose von Mikroorganismen gibt, die er als Endobionten bezeichnete.
Mit modernen Labormethoden lässt sich heute zeigen, dass zusätzlich zu den bisher bekannten Bakterienarten (Darmflora) eine große Anzahl sehr unterschiedlicher endobiontischer Mitbewohner in den Körperzellen des Menschen existiert. Diese Organismen liegen meistens als zellwandfreie Formen (CWD) vor, und sie werden mit mikrobiologischen Routinemethoden nicht erfasst.
Enderlein konnte diese CWDs bereits vor 100 Jahren mit Hilfe der dunkelfeldmikroskopischen Untersuchung des Blutes direkt beobachten.
Verschiedene Ursachen können die Entwicklung von unseren in Symbiose lebenden Endobionten in krankmachende Formen begünstigen:
chronischer Stress
Ernährungsfehler
Infektionen
Seelische Depression / emotionale Disharmonien
Medikamente
Naturwidrige Umweltverhältnisse
Diese Ursachen führen zu Veränderungen des gesunden Milieus (Verschiebung des Säure-Basen Haushalts und Schwächung des Immunsystems). Die Endobionten leben dann nicht mehr mit unserem Körper in Einklang, sondern können diesem dann erhebliche Beschwerden machen und Krankheiten auslösen.
Mit Hilfe des Dunkelfeldmikroskops ist es möglich, den Status der körpereigenen Symbionten zu betrachten und gegebenenfalls eine isopathische Theraie nach Enderlein einzuleiten, um die Symbionten wieder in ihr ursprüngliches Gleichgewicht zurückzuführen.